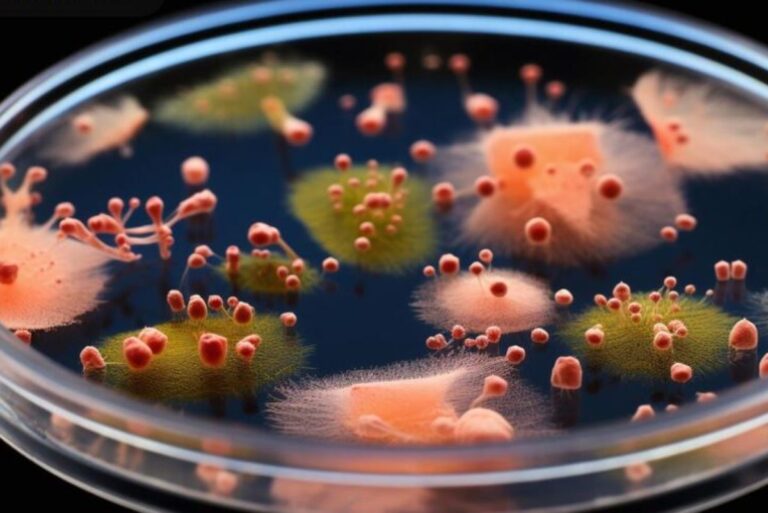

Il Citrobacter è un genere di batteri appartenente alla famiglia delle Enterobacteriaceae, noto per causare infezioni gastrointestinali negli esseri umani.
Questi batteri possono essere presenti nell'ambiente, come nel suolo e nell'acqua, ma possono anche colonizzare l'intestino umano, causando infezioni.
La trasmissione avviene principalmente attraverso il contatto con superfici contaminate o cibi e bevande non correttamente trattati.
In alcuni casi, le infezioni possono essere più gravi e coinvolgere altre parti del corpo. In questo articolo vedremo come si trasmette, quali sono i sintomi più comuni e le cure disponibili.
Il Citrobacter è un genere di batteri gram-negativi a forma di bastoncino, dotati di flagelli che li rendono mobili, e privi di spore.
Sono anaerobi facoltativi, il che significa che possono vivere sia in presenza che in assenza di ossigeno, e sono noti per la loro capacità di scomporre il citrato, da cui deriva il loro nome. Inoltre, questi batteri sono in grado di scomporre il lattosio, caratteristica che li classifica come batteri coliformi.
Una delle caratteristiche distintive del Citrobacter è la reazione positiva alla catalasi e negativa al test dell'ossidasi. Questi batteri sono diazotrofici, ovvero possono fissare l'azoto, e si trovano comunemente nel suolo e nell'acqua. Inoltre, fanno parte della flora intestinale naturale dell'uomo.
Tra le undici specie attualmente identificate, Citrobacter freundii e Citrobacter koseri sono le più rilevanti dal punto di vista clinico.
Dal punto di vista clinico, le infezioni da Citrobacter sono rare e tendono a colpire persone immunocompromesse, dove possono agire come patogeni opportunisti.
Queste infezioni si verificano principalmente come infezioni nosocomiali (acquisite in ambiente ospedaliero), con un'alta incidenza di infezioni intra-addominali. In alcuni casi, possono causare infezioni del tratto urinario o respiratorio, nonché meningite e sepsi nei neonati.
La diagnosi delle infezioni causate dal batterio Citrobacter si effettua attraverso diverse tecniche di laboratorio. Un metodo comune è la crescita del batterio in colture liquide, oppure utilizzando terreni di coltura selettivi. Questi approcci permettono di isolare e far crescere il batterio per identificarlo con precisione.
L'identificazione finale del Citrobacter si basa su metodi biochimici, come l'uso di serie di reazioni colorate, o attraverso tecniche di biologia molecolare. Queste metodologie consentono di confermare l'identità del batterio con elevata accuratezza.
Un'altra tecnica diagnostica è la rilevazione sierologica, che si basa sull'identificazione di specifici anticorpi contro il Citrobacter nel sangue.
Nel complesso, la diagnosi di infezioni da Citrobacter richiede un approccio attento e una combinazione di tecniche per garantire un'identificazione accurata e affidabile dell'agente patogeno.
Le infezioni causate da Citrobacter possono manifestarsi con una serie di sintomi diversi, a seconda dell'organo coinvolto. Ecco alcuni dei sintomi comuni:
Se sospetti un'infezione da Citrobacter, è essenziale consultare un medico per una diagnosi accurata e un trattamento adeguato. La gestione tempestiva è fondamentale per prevenire complicazioni gravi e migliorare la prognosi.
Modalità di trasmissione:
La terapia per le infezioni da Citrobacter viene determinata in base ai risultati dell'antibiogramma, un test che verifica la sensibilità del batterio agli antibiotici. In genere, il trattamento prevede la somministrazione di farmaci come chinoloni, ureidopenicilline o cefalosporine.
Questi antibiotici sono comunemente usati per combattere le infezioni batteriche e sono selezionati in base alla risposta del batterio al test dell'antibiogramma. La scelta dell'antibiotico giusto è fondamentale per garantire un trattamento efficace e ridurre il rischio di sviluppare resistenze.
Il tuo indirizzo email non sarà pubblicato.
I campi obbligatori sono contrassegnati con *